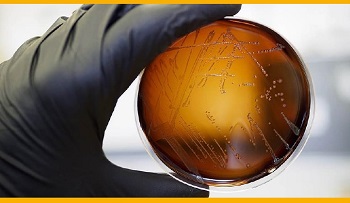

La globalización y la emergencia de nuevas enfermedades han provocado que, en los últimos años, se haya producido un incremento de los casos de zoonosis, es decir, aquellas enfermedades que se transmiten de los animales al hombre, directa o indirectamente. En ocasiones puede llegar a producirse contagio entre personas, poniendo en riesgo la salud pública mundial, como ha sido el caso de la actual epidemia de coronavirus originada en China.
Con el objetivo de dar visibilidad a los riesgos de contraer estas patologías en el entorno laboral, principalmente en los sectores de ganadería, industria alimentaria, matarifes y actividades veterinarias, MC MUTUAL organiza la jornada “Zoonosis: ¿Estamos preparados?” en la que, de la mano de diferentes especialistas, se abordarán los riesgos que conllevan los puestos de trabajo en contacto con animales y sus productos y se expondrán los métodos de evaluación y las medidas preventivas que deben aplicarse para evitar el contagio.
Además, se analizará la actual situación de emergencia provocada por el coronavirus y los efectos de la globalización en su rápida expansión.
La jornada contará con la presencia de Elena Juanola, directora del Institut Català de Seguretat i Salut Laboral del Departament de Treball, Afers Socials i Famílies de la Generalitat; Marta Zimmerman, directora del Departamento de Investigación e Información del Instituto Nacional de Seguridad y Salud en el Trabajo; Ad de Rooij, asesor médico de la Fundación para el cuidado de la salud en el sector agrícola de los Países Bajos (STIGAS); Mariano Domingo, investigador del Centro de Investigación en Sanidad Animal del IRTA; Mª Eugenia López, médica del trabajo en el Instituto Valenciano de Seguridad y Salud en el Trabajo; Júlia Vergara-Alert, investigadora del Centro de Investigación en Sanidad Animal del IRTA (Grupo coronavirus).
El evento tendrá lugar el 19 de febrero a las 9:15 h en la sede central de MC MUTUAL en Barcelona (Av. Diagonal, 394).
www.mc-mutual.com/gestionEventos/eventos/detallesEvento.do?eventoId=6661